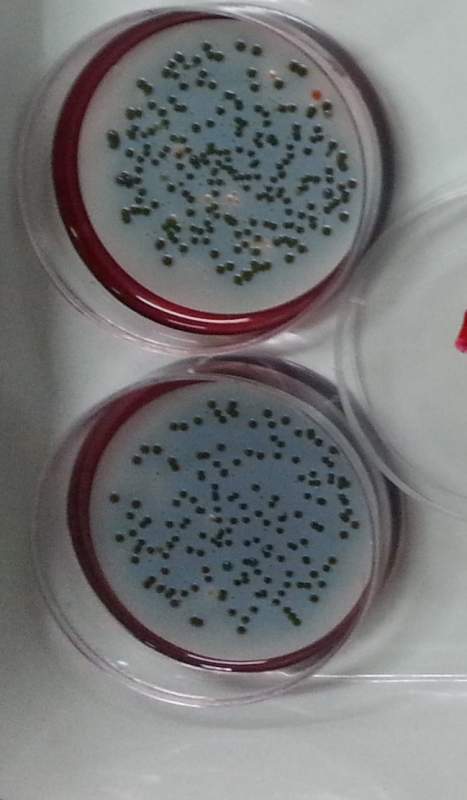
滤膜法测大肠杆菌

滤膜法

测定水样是否符合饮用水的卫生标准,常用滤膜法测定大肠杆菌的总数.
图片尺寸541x186
检验水样中大肠杆菌数目是否符合生活饮用水卫生标准,常用滤膜法测定
图片尺寸594x215
2】测定水样是否符合饮用水卫生标准,常用滤膜法测定大肠杆菌的数目
图片尺寸486x209
这里为大家介绍一下膜过滤法:降低微生物含量的方法有那些?
图片尺寸1080x563
滤膜法测大肠杆菌
图片尺寸467x800
3】测定水样是否符合饮用水卫生标准,常用滤膜法测定大肠杆菌的数目
图片尺寸497x179
2 水的净化 课件(人教版九年级上)(4)ppt
图片尺寸1080x810
2-2007食品和水中肠球菌检验方法第2部分:滤膜法
图片尺寸700x1000
滤膜制作流程
图片尺寸373x499
石墨烯小知识hummers法制备go过程中的常见问题洗涤篇
图片尺寸1000x722
水污染控制工程第八章生物膜法4baf计算演示课件
图片尺寸920x690
生物膜法之baf
图片尺寸1172x697
家庭净饮水处理常用的几种方法
图片尺寸800x438
取下滤杯,用无菌镊夹取滤膜,转移至配置好的固体培养基上,菌面朝上
图片尺寸726x361
3大肠菌群平板计数法检验程序微生物限量检测设备介绍说明,欢迎联系
图片尺寸865x396
培养反应35-37°c培养18-24小时后观察如下:大肠杆菌: 蓝色(滤膜上)
图片尺寸578x554
活性污泥法;2. 生物膜法
图片尺寸1080x810
《排水工程》第5章 生物膜法ppt
图片尺寸1080x810
活动作品cicc在线课堂水质微生物实验操作演示滤膜法
图片尺寸960x600
污水处理 │ 带你深度揭秘膜分离技术!
图片尺寸639x310